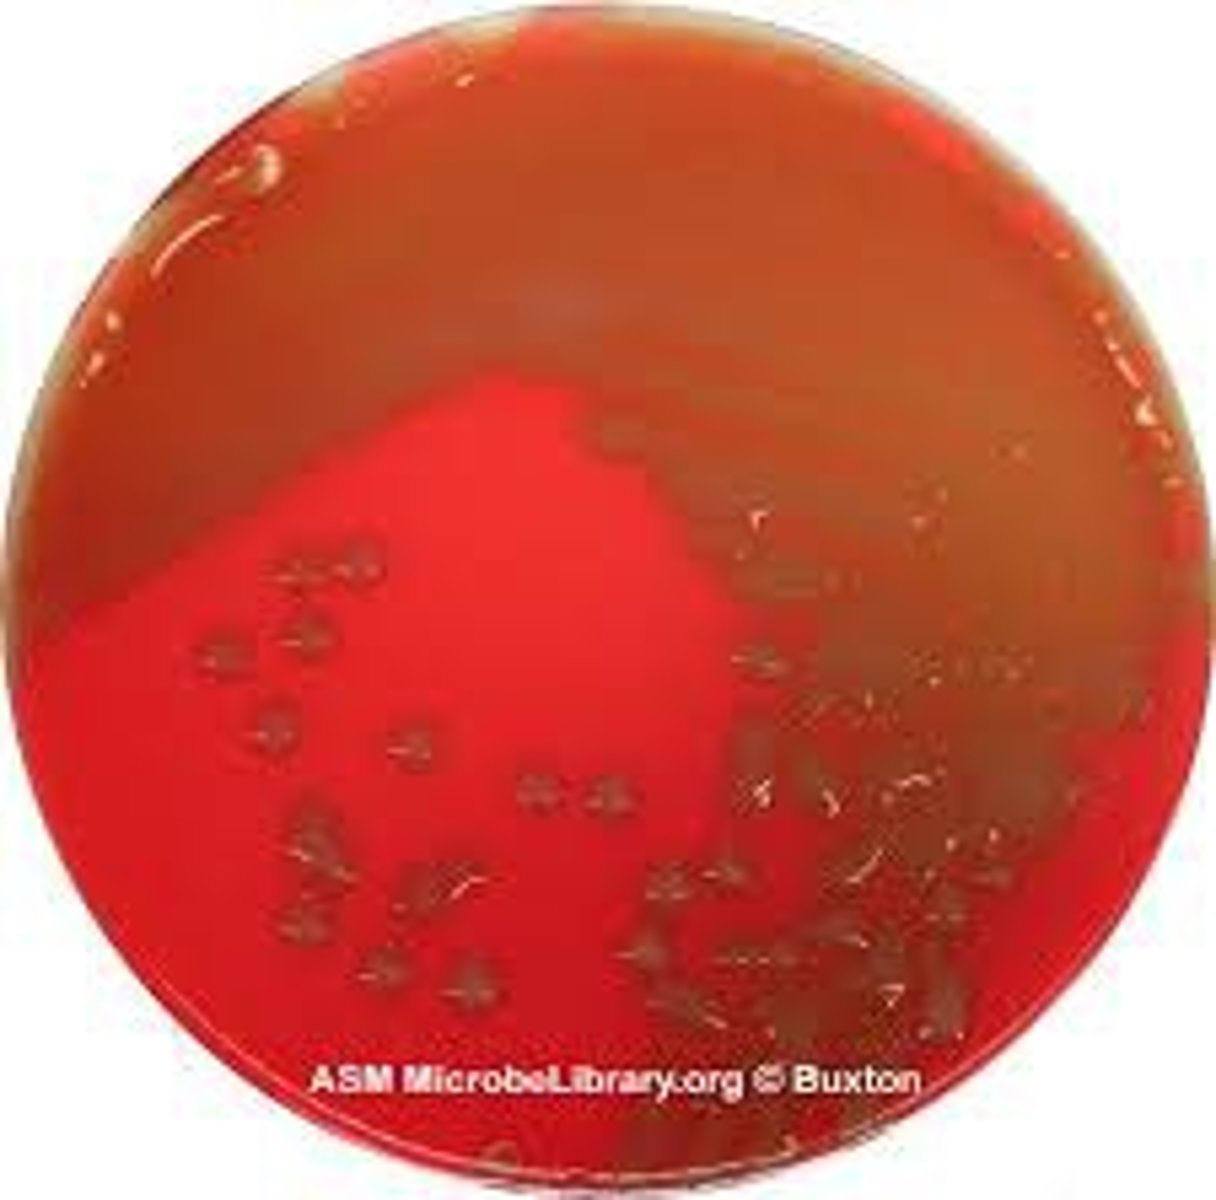
<p>incomplete lysis of red blood cells, colonies show green color</p>
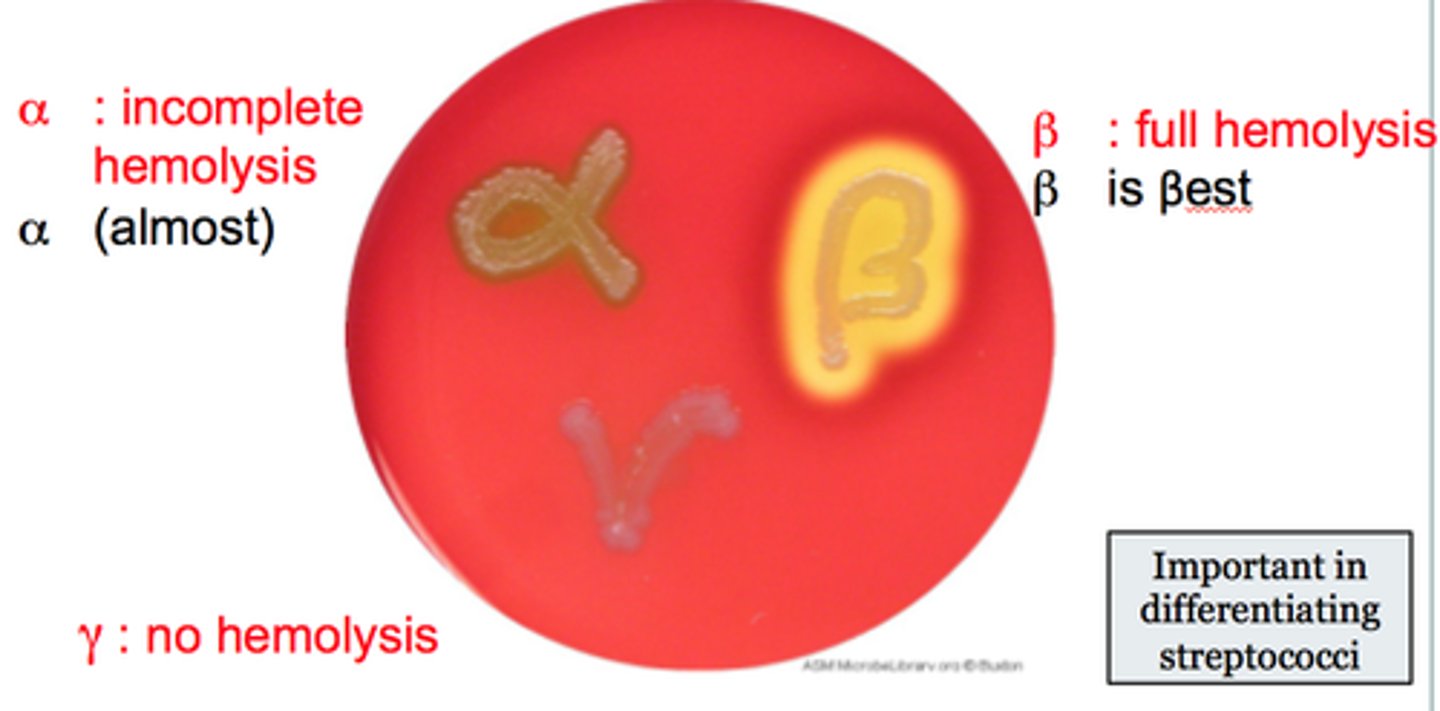
<p>can be further categorized into groups A through T based on antigenic cell wall carbohydrates</p>
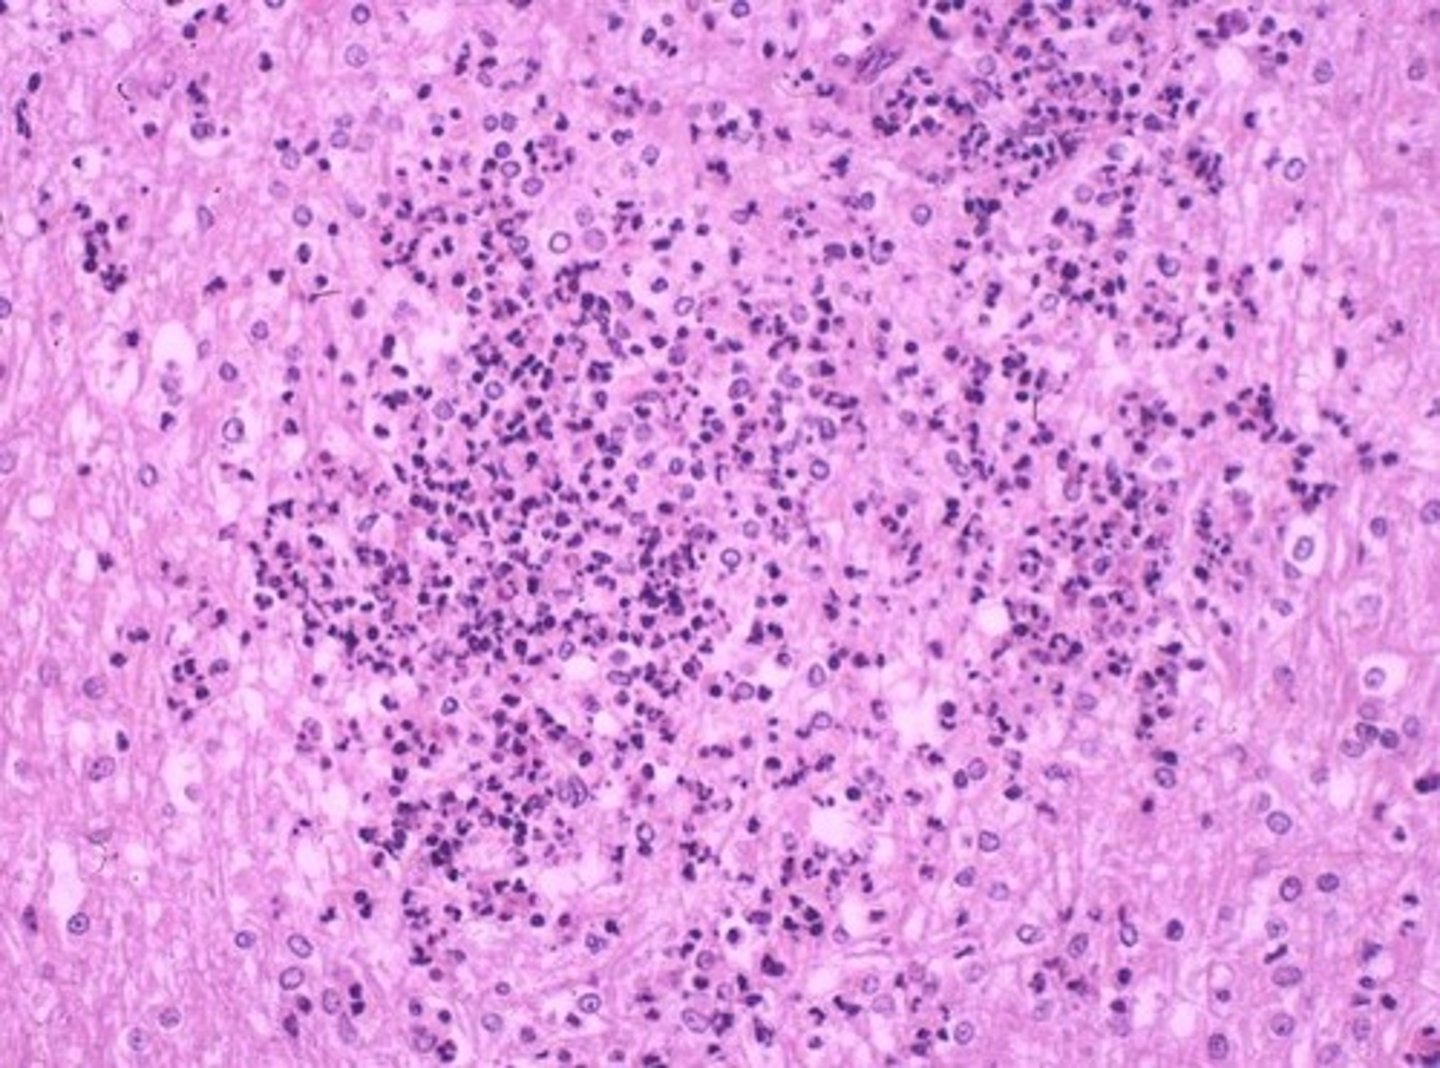
<p>1. Usually foodborne but meningitis more common in the immunocompromised individuals</p><p>2. Can invade the bloodstream, causing sepsis</p><p>3. Reproduces in phagocytes (Spreads phagocyte-to-phagocyte)</p><p>4. Infects pregnant women, crossing the placenta and leading to stillbirth</p>
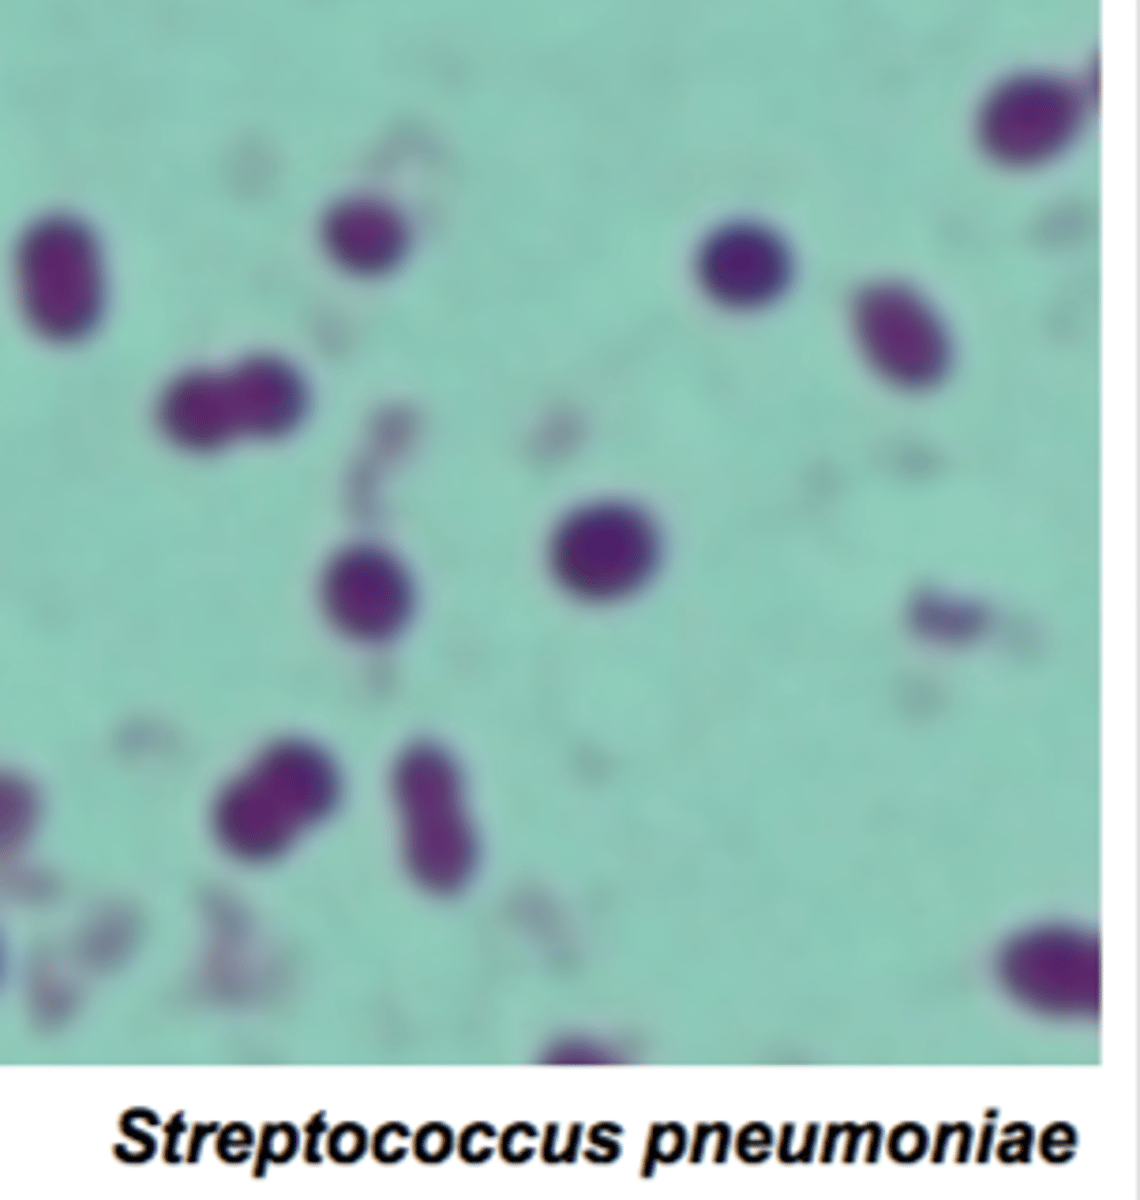
<p>1. Seventy percent of people are healthy nasopharyngeal carriers</p><p>2. Also causes pneumonia and otitis media (infection of the middle ear)</p><p>3. Most common in children (1 month to 4 years)</p><p>4. Mortality: 8% in children, 22% in the elderly</p>

Microbiology Exam #4
1/280
There's no tags or description
Looks like no tags are added yet.
Name | Mastery | Learn | Test | Matching | Spaced | Call with Kai |
|---|
No analytics yet
Send a link to your students to track their progress
281 Terms
Structure and Function of Skin: What is contained in the Stratum corneum?
Keratin, waterproofing protein layer, and dead cells

What is the epidermis?
thin outer portion of skin; composed of layers of epithelial cells

What is the dermis?
inner, thick portion of skin; composed mainly of connective tissue

What does sweat contain that provides moisture and nutrients for growth?
salts, lysozyme and antimicrobial peptides that inhibit microbes

What does sebum secreted by oil glands contain?
fatty acids that inhibit pathogens

What is a unique property of the normal microbiome of the skin?
Resistant to drying and high salt concentration

What are the two genuses of gram-positive cocci that the skin microbiome has?
Staphylococci, Micrococci
Where are the areas of the skin microbiome that have higher populations?
areas with higher moisture (ex. armpits)
metabolize sweat and contribute to body odor

What is the function of Propionibacterium acnes?
inhabits hair follicles, use secretions from the oil glands as nutrition
Produce acids that maintain low skin pH (at pH 3-5)

What causes dandruff on the skin?
Malassezia furfur (yeast organism) grows on oily skin secretion

What is the common cause of skin infections?
Staphylococcus and Streptococcus species
How do Staphylococci cause skin infections?
form irregular clusters, many produce coagulase

What are coagulases?
Enzyme that clots fibrin in the blood → induces blood clots

Does Staphylococcus epidermidis express coagulase?
No

What does Staphylococcus epidermidis inhibit and when does it cause disease?
Inhibits S. aureus or other bacteria (Propionibacterium acnes) that are more pathogenic, might causes diseases only when there is wound or low immunity

What are the properties of Staphylococcus aureus?
1. Carried in the nasal passages of 20% of the human population; 60% population occasionally carries
2. Golden-yellow colonies
3. Coagulase-positive
4. May produce damaging toxins and cause sepsis
5. Avoids host defenses; secretes proteins and toxins that kill phagocytic cells
6. Methicillin Resistant S. aureus (MRSA) strains are resistant to penicillin-like antibiotics.

Staphylococcus aureus skin infections: Folliculitis
infections of hair follicles (pimples)

Staphylococcus aureus skin infections: Sty
folliculitis of an eyelash

Staphylococcus aureus skin infections: Impetigo
crusting (nonbullous) sores, further spread to nearby areas

What are the properties of Impetigo infection?
1. Affects children 2-5 years old
2. Highly contagious; spread by direct contact
3. Streptococcus pyogenes can cause impetigo, too

What are exfoliative toxins?
proteases that can digest the connective proteins in the skin and cause skin to peel off

What are the two exotoxins that S. aureus produces?
Exfoliative toxin A - bullous impetigo
Exfoliative toxin B - circulates to distant sites and causes scalded skin syndrome

What are the symptoms of toxic shock syndrome?
Fever, vomiting, shock, and organ (ex: kidney) failure caused by toxic shock syndrome toxin 1 (TSST-1) in the bloodstream

What is the involvement of toxic shock syndrome toxin 1 (TSST-1)?
acts as superantigen to induce overreactive immune responses that cause toxic shock syndrome

What is the main action in Streptococcal skin infections?
Produce hemolysins (exotoxin) that lyse red blood cells (but other host cells, too)
Alpha-hemolytic streptococci appearance
incomplete lysis of red blood cells, colonies show green color
Beta-hemolytic streptococci appearance
complete lysis of red blood cells; clear halo around colonies

Beta-hemolytic streptococci often cause disease
can be further categorized into groups A through T based on antigenic cell wall carbohydrates
Gamma-hemolytic streptococci appearance
Not hemolytic

Group A streptococci (GAS - Streptococcus pyogenes): What virulence factors do they produce?
1. Streptolysins - lyse RBCs
2. M proteins - promote colonization on host mucus, immune system avoidance by preventing phagocytosis
3. Hyaluronidase - dissolves connective tissue
4. Streptokinases - dissolve blood clots

Staphylococcus pyogenes skin infections: Erysipelas
S. pyogenes infects the dermal layer of the skin - Causes local tissue destruction and causes sepsis if the bacterium enters blood stream

Staphylococcus pyogenes skin infections: Necrotizing fasciitis
“Flesh-eating” disease - Caused by host immune system overreacts to S. pyogenes pyrogenic toxins

Staphylococcus pyogenes skin infections: Streptococcal toxic shock syndrome
Similar to staphylococcal TSS - Exotoxin A produced by S. pyogenes acts as a superantigen
What are the properties of Pseudomonas aeruginosa?
1. Gram-negative (aerobic)
2. Pyocyanin produces a blue-green pus
4. Pseudomonas dermatitis - Self-limiting rash acquired in swimming pools
5. Otitis externa - “Swimmer’s ear
6. cystic fibrosis or burn patients; immunocompromised individuals
7. Resistant to many antibiotics (CDC serious threat list)

What is acne?
Skin cells shed in the hair follicles and combine with sebum→ Causes blockages

How is sebum formation affected?
Sebum formation is affected by hormones, not diet.

Comedonal (mild) acne
Easily treated with topical formations

Inflammatory (moderate) acne - What is it caused by and what does it do?
Caused by Propionibacterium acnes (Gram positive)
Metabolizes sebum; fatty acids produce an inflammatory response

Inflammatory (moderate) acne - How is it treated?
Treated with antibiotics and benzoyl peroxide (produce reactive oxygen species to kill P. acnes; also inhibits sebum production)

How are Viral Diseases of the Skin transmitted? Where do they cause the most problems?
Many are transmitted via respiratory routes and are systemic
Many cause problems in children and developing fetuses
What are warts and how are they transmitted?
Papillomas: small skin growths, transmitted via contact

How are warts caused?
Caused by papillomavirus (human papilloma virus; HPV) - Highly common sexually transmitted infection (STI)

What are low risk HPVs?
cause warts on skin, genitals, anus, mouth or throat

What are high risk HPVs?
High risk HPVs cause skin and cervical cancers (HPV16, HPV18)

How are skin warts treated?
Skin warts are treated with cryotherapy (liquid nitrogen), electrical currents (electrodesiccation), salicylic acid, or laser

What family is Variola virus in?
orthropoxvirus

What are the two forms of Variola virus?
Variola major has 20-60% mortality
Variola minor has <1% mortality

How is Variola virus transmitted?
Transmitted via the respiratory route, moves into the bloodstream, and infects the skin

When and how was Variola virus eradicated?
Completely eradicated from the human population by vaccination with vaccinia virus (cowpox virus; also in the orthropoxvirus family) in 1980

What viruses are Monkeypox related to?
Related to smallpox virus and cowpox virus
(all in the same virus family and have highly similar proteins)

Where is Monkeypox endemic to? How is it prevented?
Endemic to small animals in Africa, Jumps from animals to humans
Prevention by the smallpox vaccination
What are the properties of Chickenpox (Herpesvirus varicella-zoster
(human herpes virus 3; HHV3))?
1. Transmitted via the respiratory route
2. Causes pus-filled vesicles
3. Virus becomes latent in the central nerve ganglia
4. Prevented by a live attenuated vaccine (CDC
recommends for children 1-1.5 yrs for 1st does, 4-6
yrs for 2nd dose)

What is Reye's syndrome?
severe complications of chickenpox; vomiting and brain dysfunction

What are the properties of Shingles (herpes zoster)?
1. Reactivation of the latent varicella-zoster virus (HHV3) that
moves along peripheral nerves to the skin, due to lower stress or immunity
2. Follows the distribution of affected cutaneous sensory nerves; Limited to one side of the body
3. Prevention via the zoster vaccine, antiviral drugs (ex: Acyclovir) may lessen symptoms

Human herpesvirus 1 (HSV-1) and 2 (HSV-2)
HSV-1 is spread primarily by oral or respiratory routes
HSV-2 is spread primarily sexually (genital herpes)
Usually develop as cold sores or fever blisters (not the cause of canker sores)

What are some other properties of HSV-1 and HSV-2?
1. Ninety percent of the U.S. population is infected with HSV-1
2. HSV-1 remains latent in trigeminal nerve ganglia; outbreaks are triggered by the sun, stress, or hormonal changes
3. HSV-2 remains latent in sacral nerve ganglia near the spine (pelvic ends)

What is Herpetic whitlow?
vesicles and blisters on the fingers by HSV-1
Treated with acyclovir

What is Herpes encephalitis?
virus spreads to the brain (by both HSV-1 and HSV-2)
high death rates (up to 70% by HSV2 if not treated)
Treated with acyclovir

How are measles caused?
Caused by measles virus (Measles morbillivirus, MeV)

What are the properties of measles?
1. Viral disease transmitted by the respiratory route
2. Highly contagious! Cold-like symptoms, macular rash
3. Koplik's spots: Red spots on the oral mucosa
4. Prevented by the MMR (measles, mumps, rubella) vaccine

How often is occurrence of Subacute sclerosing panencephalitis?
Rare; occurs 1 to 10 years after measles recovery

What are the properties of Rubella?
1. Macular rash and light fever
2. Transmitted via the respiratory route; 2- to 3-week incubation
3. Prevented by the MMR vaccine (Protective for at least 15 years, not recommended for pregnant women)

What is Congenital rubella syndrome?
1. Pregnant women contracted Rubella virus
2. Infants with fetal damage, deafness, heart defects, mental retardation in 35% of cases
3. 15% mortality within first year of life

Other Viral rashes: Fifth disease (erythema infectiosum)
Human parvovirus B19
Mild flulike symptoms; "slapped-cheek" facial rash

Other Viral rashes: Roseola
Human herpesviruses 6 and 7
High fever; body rash; recovery within 1 to 2 days

Other Viral rashes: Hand-foot-and-mouth disease
1. Enteroviruses
2. Spread via mucous or saliva (usually children)
3. Fever and sore throat; rash and blisters on the hands, feet, mouth, and tongue
4. Could lead severe symptoms and death (not common)

What is mycosis?
fungal infection of the body

What are Cutaneous mycoses fungal infections?
Colonize the hair, nails, and outer epidermis; metabolize keratin

What are Dermatomycoses?
Informally known as tineas or ringworm
Tinea capitis: scalp ringworm
Tinea pedis: athlete's foot

What genera of fungi are involved in fungal infections of the skin?
Microsporum and Epidermophyton

How are fungal skin infections typically treated?
Treatment is usually topical drugs (miconazole and clotrimazole)

What is Candidiasis? How does it result?
Overgrowth of Candida albicans (yeast); Forms pseudohyphae, making it resistant to phagocytosis
Results when antibiotics suppress competing bacteria or a change occurs in the mucosal pH

Where does Candidiasis occur?
Occurs in skin and mucous membranes of the genitourinary tract and mouth (Thrush)

What is Conjunctivitis?
An inflammation of the conjunctiva, also called red eye or pinkeye

How is conjunctivitis caused?
Commonly caused by Haemophilus influenzae, a Gram negative bacterium (This bacterium is NOT the same as influenza viruses)

What is the conjunctivitis caused by P. aeruginosa?
Pseudomonas aeruginosa causes conjunctivitis associated with poor hygiene of contact lenses

How is Ophthalmia Neonatorum caused? What does it lead to? How does it get transmitted?
Caused by Neisseria gonorrhoeae, a Gram negative bacterium - may lead to blindness
Transmitted to a newborn’s eyes during passage through the birth canal

How is Ophthalmia Neonatorum treated? What does the treatment target?
Prevented by treating a newborn’s eyes with antibiotics;
for example erythromycin
Erythromcyin targets 50S subunit of bacterial ribosome to inhibit protein translation in bacteria

How is Inclusion Conjunctivitis caused? How does it get transmitted/spread?
Caused by Chlamydia trachomatis
Transmitted to a newborn’s eyes during passage through
the birth canal, spread through swimming pool water

Other Infectious Diseases of the Eye: Keratin
Inflammation of the cornea (not conjunctiva)
Bacterial pathogens, ex: Pseudomonas aeruginosa is a common cause in the US

Other Infectious Diseases of the Eye: Herpetic keratitis
Caused by herpes simplex virus 1 (HSV-1)
Infects cornea and may cause blindness

Other Infectious Diseases of the Eye: Acanthamoeba keratitis
Amoeba transmitted via water and soil
Associated with unsanitary contact lenses
May require a corneal transplant

What comprises the central nervous system (CNS)?
brain and spinal cord

What comprises the Peripheral nervous system (PNS)?
nerves that branch from the CNS

What is the Blood–brain barrier (BBB)?
Tightly connected cell layers surrounding the blood vessels in the CNS (crucial immunological feature)

What does the BBB do?
Prevent penetration of microbes and even molecules that can pass in normal blood vessels

How do drugs and the BBB interact? What is an example of a drug?
Drugs for treating infection in the CNS need to be able to pass the blood-brain barrier
ex. Chloramphenicol, a lipid-soluble antibiotic, can pass the BBB

What protects the brain and spinal cord?
Meninges

What is in the Subarachnoid space?
cerebrospinal fluid (CSF)

What is meningitis?
inflammation of the meninges

What are the properties of meningitis?
1. Caused by bacteria or viruses
2. Initial symptoms of fever, headache, and a stiff neck
3. Followed by nausea and vomiting
4. May progress to convulsions and coma
5. Death from shock and inflammation

What is Encephalitis?
inflammation of the brain

What is Meningoencephalitis?
inflammation of both meninges and brain

What are the properties of Haemophilus influenzae Meningitis?
1. Does NOT cause influenza (flu); Can enter the bloodstream
2. Pathogenicity due to capsule polysaccharides (antigen type b)
3. Occurs mostly in children (6 months to 4 years)
4. Accounts for 45% of bacterial meningitis cases; 6% mortality

How is Haemophilus influenzae Meningitis prevented?
Prevented by the Hib vaccine; recommended by CDC for children <5 yrs.

How does Meningococcal Meningitis begin?
1. Begins as a throat infection, rash, and bacteremia
2. Mortality of 9-12% with antibiotics; 80% without treatment
3. Vaccination protects against serotypes A, C, Y, W and B, but not X

How is Listeriosis caused?
Caused by Listeria monocytogenes (Gram-positive rod)
What are the properties of Listeriosis?
1. Usually foodborne but meningitis more common in the immunocompromised individuals
2. Can invade the bloodstream, causing sepsis
3. Reproduces in phagocytes (Spreads phagocyte-to-phagocyte)
4. Infects pregnant women, crossing the placenta and leading to stillbirth
What are the properties of Streptococcus pneumoniae Meningitis (Pneumococcal Meningitis)?
1. Seventy percent of people are healthy nasopharyngeal carriers
2. Also causes pneumonia and otitis media (infection of the middle ear)
3. Most common in children (1 month to 4 years)
4. Mortality: 8% in children, 22% in the elderly
How is Streptococcus pneumoniae Meningitis prevented?
Prevented by conjugated vaccine